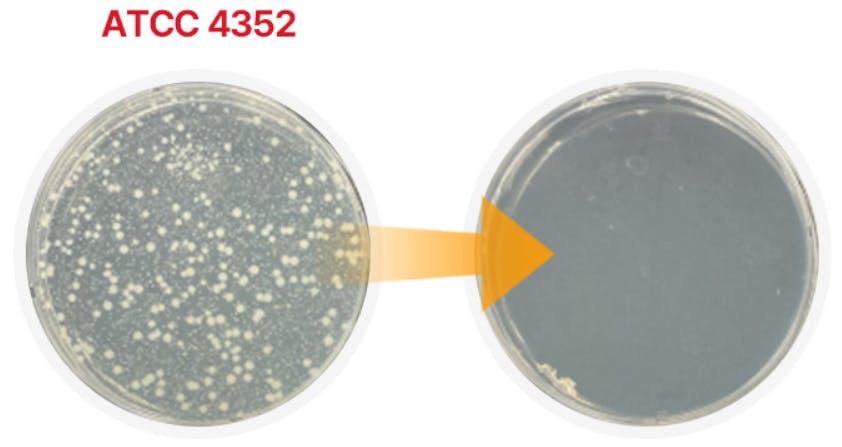

「チャブーム芳香剤」
原因をわからない車内悪臭で悩んでいませんか?
あなたの運転環境をより快適で安全にする「チャブーム芳香剤」を紹介します!
チャブームは複雑な操作を必要せず、
【ワンタッチ】で【10分放置】するだけで
エアコンの
嫌な臭いを!カビを!タバコ臭いを!細菌を! これ一本でお悩み解決!
韓国の最大ショッピングフラットフォーム
「NAVER」 Smart Store レビュー約500件以上! 4.9/5の使用満足度!
#変な臭い #タバコ臭い #車内細菌 #夏 #エアコン #車内悪臭
プロダクトのご紹介
◎ワンタッチ放置で完全除臭:
混ぜて!押して!置いて!エアコンを内部循環に!
10分置くだけで簡単に除臭と除菌効果が!


◎完全除菌:
車両内の色んなところに生息している有害細菌

敗血症の原因となる緑膿菌!
アレルギーの原因となるクラドスポリウム菌!
食中毒の原因となるブドウ球菌!
皮膚疾患の原因となるレンサ球菌!
有害細菌

手が届かないところまで!除菌・消臭効果を証明!

◎長い持続性:10分で3週間フィトンチッド香が続く!
高濃度のフィトンチッドオイル含有で3週間フィトンチッド香
◎高い安全性・満足度:国家機関FITIの安全検査適合判定!
芳香剤としての安全性認証!除菌認証!
NAVERレビュー数 500個!4.9/5の高い使用満足度
※チャブーム芳香剤は当社の独自配合技術を用いた
特許のオリジナル商品です!
こんな方にオススメ!
※中古車を購入した方
※喫煙者の方
※車を買った友人にプレゼントしたい方
使用方法
※使用する前に車を次のようにセッティングしてください
車のセッティングが終わったら

リターンのご紹介
CAMPFIRE価格!
1個 2,300円
2個セット購入 4,500円
3個セット購入 6,300円
製品情報・仕様
商品名: チャブーム芳香剤
サイズ: 7cm x 13cm (直径 x 高さ)
重量: 150g
重要性分: エタノール、フィトンチッドオイル(檜、柏槙)
用途: 脱臭剤、芳香剤、車内抗菌
(梱包サイズは130mmx100mmx80mm(幅x奥x高さ)の紙ボックスを使います。)
注意事項
・子供の手が届かない所に保管して下さい。
・車内および零下の温度には保管しないで下さい。
・人に向けて直接噴射しないで下さい。
・密閉された空間で使用する場合は、換気を十分にして下さい。
・他の製品と混合せずご使用下さい。
・直射日光や熱にさらされると火災の恐れがあります。
・表示事項に記載された製品の用途以外は使用しないでください。
Q&A
1. 香はどのくらい続きますか?
A: 1個基準、約3週間続きます!
2. 子供にも安全ですか?
A: 国際認証機関FITIがチャブームの安全性を保証しています。
3. 車だけ使えますか?
A: いいえ、室内のエアコンにもお使い頂けます。
4. 使用時間はどのくらいですか?
A: 1個基準、約10分かん放置です!
5. 使用後、シートなどの変色はありますか?
A: 本商品による変色はありませんが、直接表面にはあたらないようにご使用ください。
<募集方式について>
本プロジェクトはAll-in方式で実施します。目標金額に満たない場合も、計画を実行し、リターンをお届けします。






コメント
もっと見る